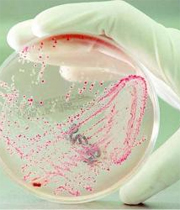
Imagen

Las bacterias E. coli resistentes a los antibióticos son mucho más frecuentes en aldeas cercanas a carreteras que en zonas completamente rurales, según un estudio difundido este jueves por la Universidad de Michigan.
 Este hallazgo sugiere que las carreteras juegan un papel muy importante en la propagación y contención de bacterias resistentes a los antibióticos, comúnmente llamadas "súper bichos".
Este hallazgo sugiere que las carreteras juegan un papel muy importante en la propagación y contención de bacterias resistentes a los antibióticos, comúnmente llamadas "súper bichos".
"Muchos estudios sobre diversas enfermedades infecciosas demostraron el impacto de las carreteras en la propagación de enfermedades. Sin embargo, éste es el primer estudio que demuestra que las carreteras también influyen en la propagación de bacterias resistentes a antibióticos", dijo Joe Eisenberg, coautor y profesor de la Escuela de Salud Pública de la Universidad.
Los investigadores de la Universidad de Michigan, sus colegas de la Universidad San Francisco de Quito y el Trinity College en Connecticut (EEUU) estudiaron una región en el noroeste de Ecuador durante cinco años, para centrarse en la resistencia de la E. coli a los antibióticos ampicilina y sulfametoxazol.
El estudio encontró que no es tan sólo el uso del antibiótico individual el que afecta a la resistencia.
"Otros factores importantes que afectan a la propagación de la resistencia son la velocidad a la que se introducen nuevas cepas debido a movimientos desde y hacia la región, así como la mala calidad del agua y los sistemas de desagüe, que permiten la transmisión de esas cepas resistentes", añadió Eisenberg.
Multiplicación
El consumo de antibióticos durante largos periodos de tiempo puede aumentar la resistencia de las bacterias pero si se toman durante lapsos cortos hay otras consecuencias.
Las cepas no resistentes mueren, pero las resistentes que puedan alojarse en el individuo aprovechan el espacio dejado por las desaparecidas, se multiplican y se convierten en las cepas dominantes. De este modo, precisa el estudio, se aumenta la probabilidad de que ese individuo contagie a otros.
La investigación advierte de que una persona infectada puede contaminar alimentos o agua que pueden estar al alcance de otras personas, por lo que es muy importante considerar las infraestructuras y los sistemas de saneamiento.

Este hallazgo sugiere que las carreteras juegan un papel muy importante en la propagación y contención de bacterias resistentes a los antibióticos, comúnmente llamadas "súper bichos".
Este hallazgo sugiere que las carreteras juegan un papel muy importante en la propagación y contención de bacterias resistentes a los antibióticos, comúnmente llamadas "súper bichos".